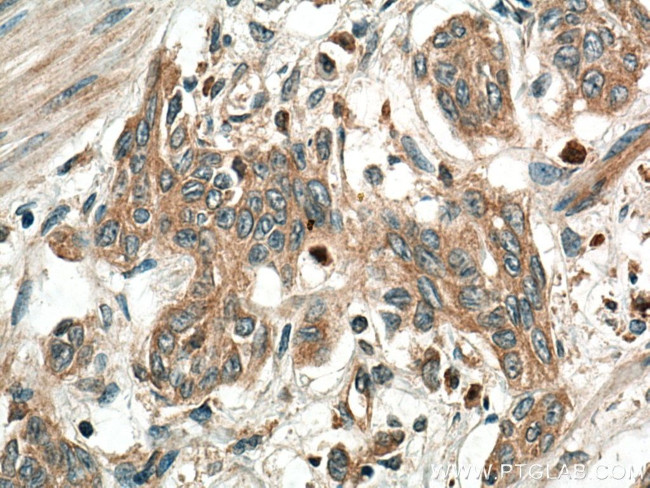
PGC Antibody in Immunohistochemistry (Paraffin) (IHC (P))

Search
Proteintech
PGC Polyclonal Antibody
{{$productOrderCtrl.translations['antibody.pdp.commerceCard.promotion.promotions']}}
{{$productOrderCtrl.translations['antibody.pdp.commerceCard.promotion.viewpromo']}}
{{$productOrderCtrl.translations['antibody.pdp.commerceCard.promotion.promocode']}}: {{promo.promoCode}} {{promo.promoTitle}} {{promo.promoDescription}}. {{$productOrderCtrl.translations['antibody.pdp.commerceCard.promotion.learnmore']}}
产品信息
28532-1-AP150UL
种属反应
宿主/亚型
分类
类型
偶联物
形式
浓度
规格
纯化类型
保存液
内含物
保存条件
运输条件
靶标信息
Pepsin is one of the main proteolytic enzymes secreted by the gastric mucosa. Pepsin consists of a single polypeptide chain and arises from its precursor, pepsinogen, by removal of a 41 amino acid segment from the N-terminus. Pepsinogen is synthesized in the stomach lining, and hydrochloric acid, also produced by the gastric mucosa, is necessary to convert the inactive enzyme and to maintain the optimum acidity (pH 1-3) for pepsin function. Pepsin is particularly effective in cleaving peptide bonds involving aromatic amino acids. Pepsin shows extremely broad specificity, and although bonds involving phenylalanine and leucine are preferred, many others are also cleaved to some extent. The amino acid composition of Pepsin C differs from those of pepsinogen and pepsin especially in the content of basic amino acids, glutamic acid, aspartic acid, leucine and isoleucine.
仅用于科研。不用于诊断过程。未经明确授权不得转售。
篇参考文献 (0)
生物信息学
蛋白别名: Gastricsin; pep carboxylase; pepcase; pepsin C; Pepsinogen C; pepsinogen group II; preprogastricsin; unnamed protein product; Urinary pepsinogen 1
基因别名: 2210410L06Rik; PEPC; Pg-1; PG1; PGC; PGII; Upg-1; Upg1
UniProt ID: (Human) P20142, (Mouse) Q9D7R7, (Rat) P04073
Entrez Gene ID: (Human) 5225, (Mouse) 109820, (Rat) 24864